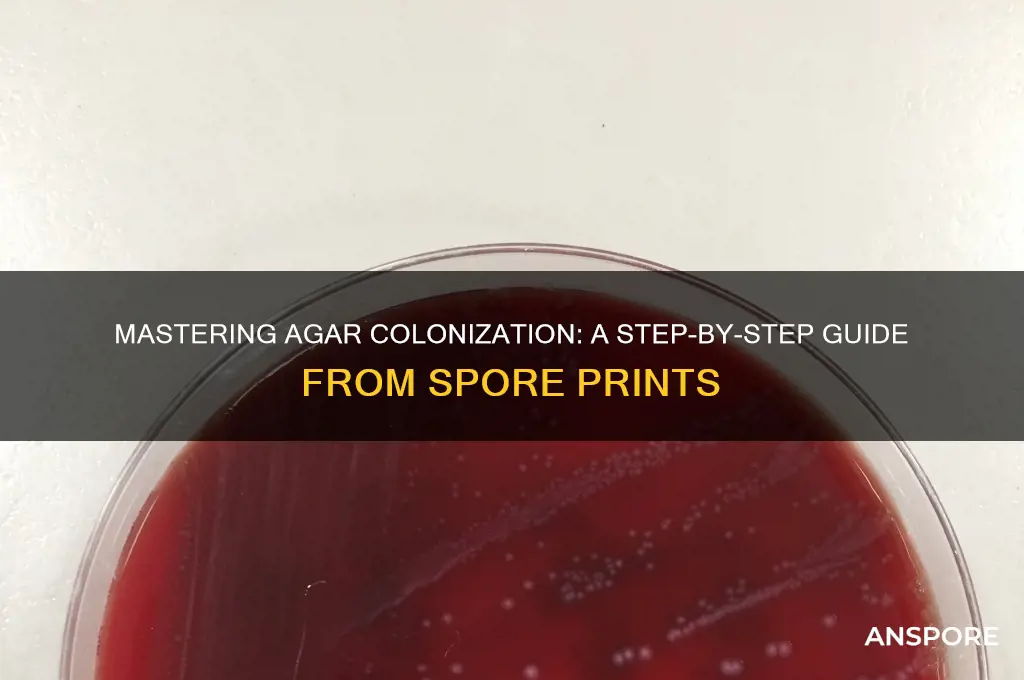
how to colonize agar from a spore print

Colonizing agar from a spore print is a fundamental technique in mycology, allowing cultivators to isolate and grow specific mushroom species in a controlled environment. The process begins by carefully transferring spores from a spore print onto a sterile agar plate, typically using a flame-sterilized inoculation loop or needle to maintain aseptic conditions. The agar medium, enriched with nutrients, provides an ideal substrate for spore germination. Once inoculated, the plate is sealed and incubated in a stable, dark environment, where spores develop into mycelium over several days to weeks. This method is crucial for studying fungal genetics, breeding new strains, or preparing cultures for further cultivation, ensuring purity and minimizing contamination risks.
| Characteristics | Values |
|---|---|
| Sterilization | Autoclave agar plates at 121°C (250°F) for 15-30 minutes to ensure sterility. |
| Agar Type | Use a nutrient-rich agar such as Potato Dextrose Agar (PDA), Malt Extract Agar (MEA), or Sabouraud Agar. |
| Spore Print Preparation | Place a mature mushroom cap gill-side down on a piece of aluminum foil or glass for 2-24 hours to collect spores. |
| Inoculation Technique | Use a sterile scalpel or inoculation loop to transfer a small portion of the spore print to the agar surface. |
| Incubation Temperature | Incubate plates at 22-28°C (72-82°F) in a dark or low-light environment. |
| Incubation Duration | Allow 7-14 days for visible colonization, depending on the mushroom species. |
| Humidity Control | Maintain high humidity (80-90%) by placing plates in a humid chamber or using a humidity-controlled incubator. |
| Contamination Prevention | Work in a sterile environment (e.g., laminar flow hood) and use proper aseptic techniques to minimize contamination. |
| Colonization Appearance | Healthy mycelium appears white, fluffy, and spreads uniformly across the agar surface. |
| Subculturing | Transfer healthy mycelium to fresh agar plates every 2-4 weeks to maintain viability and prevent contamination. |
| Storage | Store colonized agar plates at 4°C (39°F) for short-term storage or freeze-dry for long-term preservation. |
| Common Issues | Contamination by bacteria, mold, or other fungi; slow or no growth due to improper sterilization or incubation conditions. |
Explore related products
What You'll Learn
- Preparing Agar Plates: Sterilize agar, cool, pour into plates, and solidify in a clean environment
- Harvesting Spore Print: Gently scrape spores from print using a sterile scalpel or brush
- Inoculating Agar: Transfer spores to agar surface using flame-sterilized tool or swab
- Incubating Plates: Store plates in a warm, dark place for spore germination and growth
- Monitoring Growth: Check daily for mycelium development, ensuring no contamination occurs

Preparing Agar Plates: Sterilize agar, cool, pour into plates, and solidify in a clean environment
Agar plates are the foundation of successful spore colonization, but their preparation demands precision. Sterilization is paramount. Autoclaving agar at 121°C (250°F) for 15-20 minutes ensures all contaminants are eradicated. This step is non-negotiable; even a single surviving microbe can compromise your entire experiment. Think of it as creating a blank canvas, free from any competing life forms, ready to be painted with your chosen fungal species.
Agar, once sterilized, must be handled with care. Cooling it to around 50-55°C (122-131°F) is crucial. Pouring molten agar directly into plates risks cracking the glass and injuring yourself. This temperature range allows for safe handling and prevents the agar from solidifying prematurely. Imagine trying to paint with thick, drying paint – it’s a recipe for frustration and uneven results.
Pouring the agar into plates requires a steady hand and a sterile environment. Work in a laminar flow hood or a still air box to minimize airborne contaminants. Pour swiftly but carefully, filling each plate to about 3-4 mm thickness. This ensures a sufficient growth medium without wasting agar. Think of it as pouring the perfect pancake batter – you want a consistent, even layer.
Once poured, allow the agar to solidify undisturbed. This typically takes 30-60 minutes, depending on the agar type and room temperature. Avoid moving the plates during this time, as it can introduce bubbles or uneven surfaces. Imagine a delicate jelly setting – any disturbance can ruin its structure.
Finally, store the solidified agar plates in a clean, dry environment until ready for inoculation. Properly prepared plates can be stored for several weeks, but always inspect them for any signs of contamination before use. Remember, the success of your spore colonization hinges on the quality of your agar plates. Treat them with the same care and attention you would give to a precious scientific instrument.
Spores Unveiled: Exploring Varieties and Their Impact on Human Life
You may want to see also

Harvesting Spore Print: Gently scrape spores from print using a sterile scalpel or brush
The delicate process of harvesting a spore print demands precision and sterility. A single misstep can introduce contaminants, derailing weeks of cultivation efforts. Here’s where the sterile scalpel or brush becomes your most critical tool. Unlike improvised instruments, these ensure minimal disturbance to the spore structure while maintaining the aseptic conditions essential for successful colonization.
Imagine the spore print as a microscopic treasure map, each spore a potential colony. The goal is to transfer this genetic material to agar without compromising its viability. A sterile scalpel, with its sharp edge, allows for controlled scraping, capturing spores without crushing them. Alternatively, a sterile brush—preferably with soft, synthetic bristles—offers a gentler approach, ideal for larger prints or species with delicate spores. Both tools must be flame-sterilized before use, ensuring no foreign organisms hitch a ride.
The technique itself is straightforward but requires a steady hand. Hold the scalpel or brush at a shallow angle, applying minimal pressure as you glide across the spore print. Work in a single direction to avoid redistributing spores unevenly. For optimal results, aim to collect spores from the densest areas of the print, typically the center, where concentration is highest. A successful harvest yields a fine, uniform powder, ready for inoculation.
Caution is paramount. Even the cleanest environment harbors invisible threats. Perform this step in a still air box or laminar flow hood if possible, and wear gloves to minimize skin contact. Contamination at this stage can render the entire process futile. Remember, spores are resilient but not invincible—rough handling or unsterile tools can reduce germination rates significantly.
Mastering this step bridges the gap between observation and cultivation. With spores safely harvested, you’re one step closer to witnessing the mesmerizing growth of mycelium on agar. Precision here pays dividends later, ensuring a robust and healthy culture.
Mastering Spore: Tricks to Bypass the Complexity Meter Easily
You may want to see also

Inoculating Agar: Transfer spores to agar surface using flame-sterilized tool or swab
A critical step in cultivating mushrooms from spore prints is the precise transfer of spores to a sterile agar surface. This process, known as inoculation, demands meticulous attention to detail to prevent contamination. The chosen tool—whether a scalpel, inoculation loop, or sterile swab—must be flame-sterilized before and after each use. Hold the tool in the flame until it glows red, ensuring all microorganisms are eradicated. Allow it to cool momentarily to avoid damaging the agar or spores, then gently touch the spore print to collect a small sample. This method ensures a controlled and sterile transfer, laying the foundation for successful colonization.
The technique for transferring spores varies depending on the tool used. For instance, a flame-sterilized scalpel can be carefully dragged across the spore print to collect a thin layer of spores, which is then delicately spread onto the agar surface in a zigzag pattern. Alternatively, a sterile swab, moistened with distilled water, can be lightly pressed onto the spore print and then dabbed onto the agar in a grid-like manner. The goal is to distribute spores evenly without overcrowding, as this can lead to uneven colonization. Consistency and gentleness are key to avoiding damage to both the agar and the spores.
One common mistake during inoculation is neglecting to work in a sterile environment. Even a flame-sterilized tool can reintroduce contaminants if the workspace is not properly sanitized. Use a laminar flow hood or a still-air box to minimize airborne particles, and ensure all surfaces are wiped down with 70% isopropyl alcohol. Additionally, wear sterile gloves and a face mask to reduce the risk of introducing human contaminants. These precautions, combined with proper tool sterilization, create a clean environment conducive to successful spore germination.
After inoculation, the agar plate must be sealed with parafilm or surgical tape to maintain sterility and prevent desiccation. Place the plate in a dark, temperature-controlled environment, ideally between 22–26°C (72–78°F), to encourage spore germination. Monitor the plate daily for signs of contamination, such as unusual colors or odors, which may indicate bacterial or mold growth. If contamination is detected, discard the plate immediately to avoid cross-contamination. With patience and precision, the spores will begin to colonize the agar within 7–14 days, forming a mycelial network that serves as the basis for further cultivation.
Inoculating agar from a spore print is a delicate balance of art and science, requiring both technical skill and an understanding of microbial behavior. By mastering the use of flame-sterilized tools and maintaining a sterile environment, cultivators can significantly increase their chances of success. This step is not just about transferring spores—it’s about creating the ideal conditions for life to flourish, setting the stage for the intricate process of mushroom cultivation.
Rehydrating Spores: Optimal Time and Techniques for Successful Revitalization
You may want to see also
Explore related products

Incubating Plates: Store plates in a warm, dark place for spore germination and growth
After inoculating agar plates with a spore print, the incubation phase is critical for successful colonization. This stage requires a controlled environment that mimics the conditions favorable for spore germination and mycelial growth. The ideal setup involves storing the plates in a warm, dark place, typically at temperatures between 22°C and 28°C (72°F to 82°F). These parameters encourage metabolic activity without stressing the spores, which can lead to uneven or failed colonization. A consistent temperature is key, as fluctuations can disrupt the growth process, so using an incubator or a stable room environment is recommended.
The choice of a dark environment is equally important. Light, particularly direct sunlight, can inhibit spore germination and promote contamination by encouraging the growth of unwanted microorganisms or algae. Wrapping the plates in aluminum foil or storing them in opaque containers ensures darkness while maintaining airflow. Avoid airtight sealing, as spores require oxygen for respiration during the early stages of growth. A balance between protection and ventilation is essential to prevent mold or bacterial contamination while fostering healthy mycelium development.
Incubation duration varies depending on the species and environmental conditions, but most plates show visible colonization within 7 to 14 days. Regularly inspect the plates for signs of growth, but minimize handling to reduce contamination risk. If contamination occurs, isolate the affected plates immediately to prevent cross-contamination. Patience is crucial during this phase, as rushing the process or over-inspecting can compromise results.
For optimal outcomes, consider using a heating pad or incubator with a thermostat to maintain precise temperatures. If using a heating pad, place it on a low setting and monitor the plates to avoid overheating. Alternatively, a warm room, such as a kitchen or closet, can suffice if the temperature remains stable. Pair this with a dark storage box or foil wrapping to create an ideal incubation environment. By adhering to these specifics, you maximize the chances of successful agar colonization from a spore print.
Understanding Spore Indicator Tests: Functionality and Applications in Sterilization
You may want to see also

Monitoring Growth: Check daily for mycelium development, ensuring no contamination occurs
Daily observation is critical during the agar colonization process, as it allows you to track the mycelium's progression and intervene at the first sign of contamination. Mycelium growth typically begins within 5-14 days, depending on the mushroom species and environmental conditions. During this period, the mycelium will appear as a white, thread-like network spreading across the agar surface. It's essential to maintain a consistent observation schedule, as neglecting this task can result in undetected contamination, which may compromise the entire culture.
To effectively monitor growth, start by examining the agar plate under adequate lighting, preferably in a well-lit room or using a magnifying glass for closer inspection. Look for subtle changes in the agar's appearance, such as discoloration or unusual textures, which may indicate contamination. Common contaminants include bacteria, mold, or yeast, often presenting as colored spots, fuzzy growth, or slimy textures. If detected early, contaminated areas can be carefully removed using a sterile scalpel or inoculation loop, preventing further spread.
A systematic approach to monitoring is recommended, involving a daily checklist to ensure thorough inspection. Record observations, including growth rate, mycelium density, and any signs of contamination. This data will help you identify trends and make informed decisions regarding the culture's progress. For instance, if mycelium growth appears sluggish, consider adjusting environmental factors like temperature or humidity. Optimal conditions for most mushroom species range from 22-28°C (72-82°F) and 60-70% relative humidity.
In addition to visual inspection, consider implementing a contamination prevention strategy. This may include using a laminar flow hood or still air box during the initial inoculation process, as well as maintaining strict aseptic techniques. Regularly clean and disinfect work surfaces, tools, and hands to minimize the risk of introducing contaminants. By combining diligent monitoring with proactive contamination prevention, you can significantly increase the chances of successful agar colonization and produce a healthy, viable mycelium culture.
As the mycelium approaches full colonization, typically within 2-4 weeks, you may notice a change in its appearance, becoming more dense and compact. At this stage, it's crucial to avoid over-observation, as frequent handling can introduce contaminants. Instead, focus on maintaining optimal environmental conditions and preparing for the next step in the cultivation process, such as transferring the mycelium to a bulk substrate or grain spawn. By following these monitoring and contamination prevention guidelines, you'll be well on your way to successfully colonizing agar from a spore print and producing high-quality mushroom cultures.
Effective Duration of Milky Spore for Repelling Moles in Your Lawn
You may want to see also
Frequently asked questions
Sterilize the agar by autoclaving it to ensure it is free from contaminants. Allow it to cool to around 50°C (122°F) before pouring it into sterile Petri dishes. Once solidified, the agar is ready for inoculation with the spore print.
Use a sterile scalpel or inoculation loop to gently scrape a small portion of the spore print. Lightly streak the spores onto the surface of the agar, ensuring even distribution. Work in a sterile environment, such as a laminar flow hood, to minimize contamination.
Maintain the inoculated agar plates in a warm, dark environment with temperatures between 22°C and 28°C (72°F–82°F). Humidity should be controlled to prevent drying. Check the plates regularly for signs of growth, which typically appears within 3–7 days.























